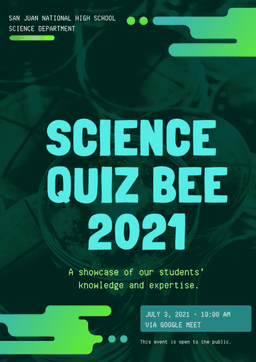
placeholder image to represent content

Feel free to use or edit a copy
includes Teacher and Student dashboards
Measure skillsfrom any curriculum
Measure skills
from any curriculum
Tag the questions with any skills you have. Your dashboard will track each student's mastery of each skill.
With a free account, teachers can
- edit the questions
- save a copy for later
- start a class game
- automatically assign follow-up activities based on students’ scores
- assign as homework
- share a link with colleagues
- print as a bubble sheet
6 questions
Show answers
- Q11. A substance that cannot be broken down into a simpler form by ordinary chemical means is called a(n) ________________.ElementMixtureIsotopeCompound30s
- Q22. A compass bearing of 165 degrees describes a _______________.South-easterly directionNorth-easterly directionNorth-westerly directionSouth-westerly direction30s
- Q33. The smallest unit of an element that has all the basic properties of the element is called a(n) ________________.IsotopeNucleusAtomElectron30s
- Q44. Plants create their own food by absorbing and processing sunlight. The ability to produce your own food source is a metabolic process known as what?DitrophyHomotrophyHeterotrophyAutotrophy30s
- Q55. Sea breezes occur during the ________ and the produce winds moving ________.Day / in over the landNight / out over the waterDay / out over the waterNight / in over the land30s
- Q61. A substance that cannot be broken down into a simpler form by ordinary chemical means is called a(n) ________________.CompoundIsotopeMixtureElement30s